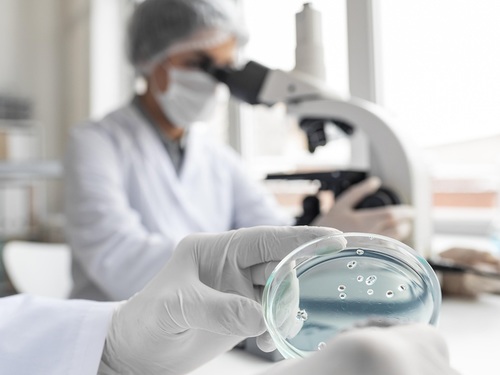

CATEGORÍA: Salud
La gripe y la resistencia a los antibióticos preocupa a los profesionales
12 octubre 2021
¿Qué pasará con la gripe? ¿Qué ocurre con los antibióticos? El Grupo de Infecciones en Urgencias de SEMES ha puesto a disposición de especialistas el programa “Más Allá del COVID”, un proyecto con el que revisar la situación actual y tratar la preocupación médica más allá de la pandemia
Elaine Fuchs, bióloga molecular e investigadora en el Howard Hugues Medical Institute: “Las células madre del cáncer pueden ser el gran obstáculo a los tratamientos”
11 octubre 2021
Aunque las terapias contra el cáncer mejoran, sigue habiendo tumores que no desaparecen o que se reproducen de nuevo. El motivo parece estar en las células madre y en su capacidad para hacerles frente. Hablamos con Elaine Fuchs, pionera en el estudio de este tipo de células en la piel, cuyo nombre aparece desde hace años en las quinielas para los premios Nobel.
Investigadores españoles logran eliminar tumores cerebrales usando un virus de los ratones
10 octubre 2021
Los virus oncolíticos son virus naturales o modificados que atacan únicamente a las células cancerígenas
Crean una ‘píldora viva’ para tratar infecciones resistentes a los antibióticos
09 octubre 2021
Investigadores españoles han utilizado bacterias modificadas genéticamente con la capacidad de producir enzimas que disuelven los biofilms, lo que supone un paso importante en el desarrollo de nuevos tratamientos contra las infecciones que afectan a los implantes médicos.
Demuestran que la covid-19 puede dañar la placenta de las mujeres embarazadas
08 octubre 2021
La afectación placentaria, causada por la infección del SARS-CoV-2, produce un comportamiento anómalo del flujo sanguíneo entre la madre y el bebé en desarrollo, debido a la necrosis del trofoblasto. Investigadores españoles han observado que, a pesar de que resulta muy infrecuente, puede ser mortal para el feto.

Farmacias abiertas y de urgencia más cercanas
Farmacias abiertas y de urgencia más cercanas